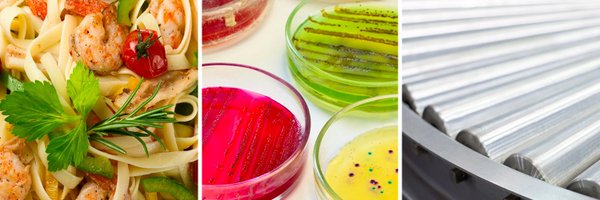
EFFoST Profile Banner

EFFoST
@EFFoST
Followers
3K
Following
2K
Media
1K
Statuses
3K
European scientific association for Food Professionals. Promoting European cooperation among food scientist, engineers, technologists and business.
The Netherlands
Joined February 2011
🤩 Day 2 of #EFFoST2025 featured 19 sessions on novel food sources, sustainable processing, packaging, and digitalisation in food systems, and six special sessions 🍷 The day closed with a gala dinner at the historic Barrons Hall, supported by @Nestle R&D.
0
0
2
🎉 We wrapped up the first day of #EFFoST2025 with the famous EFFoST Pub Quiz! Participants had the opportunity to test their knowledge in food science and technology. 🏆 Congratulations to the winning teams! Today we continue with more food science goodnes.
0
0
3
✨ @Data4Food2030 will also be part of #EFFoST2025! The project will host a Special Session exploring how data can accelerate the transition to sustainable, fair and resilient food systems. Join the session on 17 November at 16:30! 🔗Learn more: https://t.co/tzSBDCYNrU
0
0
2
📣Join the #FOODPathS special session on collaborative pathways for sustainable food systems! You can take part of this session at #EFFoST2025 to learn how collaborative partnerships and knowledge-driven action can accelerate food system transformation. 🔗 https://t.co/yLpj4ResuH
0
0
0
💥Don’t miss the @FoodDataQuestEU project special session at #EFFoST2025! Join us on Wednesday 19 November at 15:00 to explore how data, AI, and digital tools can drive sustainability, transparency, and trust across the food value chain. 🔗Learn more: https://t.co/y1Jl9JKwq1
0
0
0
📣We're thrilled to announce that the @CatalyseEU project will host a Special Session at the 39th #EFFoST International Conference! This session will highlight innovation and collaboration in food safety. 🔗Find more information about the programme: https://t.co/TXjeYXOi6l
0
1
1
🥇We have one week left until we meet in Porto for #EFFoST2025 ! Join us this year as we explore ‘Fostering the Transition to Sustainable Food Systems : Embracing Novelty and Overcoming Challenges’. 📆17-19 November, 2025 📍Porto, Portugal 🔗 https://t.co/KPIxnUPqDn
0
0
1
🥈Countdown: only two weeks until the 39th #EFFoST International Conference! Join world-renowned researchers, scientists, policy makers, professionals and students from multi-disciplinary food-related fields. 📆17-19 November, 2025 📍Porto, Portugal 🔗 https://t.co/KPIxnUPqDn
0
1
2
💥 The EYE Mentorship Programme is back! @EHEDG and #YoungEFFoST are thrilled to announce that applications are now open for the 3rd round of the EYE Mentorship Programme. 🔗 https://t.co/fN3qM5V8Li
0
0
0
🍽️ There are still some spots available for the #EFFoST2025 conference dinner! 🍷The dinner will place in The Baron’s Hall & Gallery, a majestic repurposed 18th-century Port wine warehouse in Vila Nova de Gaia. 🔗More information on our events: https://t.co/zhn8olRiz0
0
0
1
📣 Don't miss the GIANT LEAPS project Young Investigators Webinar on sustainability and dietary modelling! Focused on the tools used to better understand the impacts of alt protein sources on various dimensions of sustainability 🗓 29 Oct | 11:00 CET 📍 https://t.co/VdbJ96apFt
0
1
1
💥 #EFFoST participated in the #SynergyDays2025 representing two projects: @FoodDataQuestEU and @Data4Food2030 It was a pleasure to join other digital innovators of the European agri-food sector to connect and create more opportunities to improve food systems!
0
0
2
🥇 One month to go: #EFFoST2025 is almost here! 🔬Conference delegates will have the opportunity to visit @BiotecCatolica and CBQF Research Center. Places are limited, so make sure to secure your spot! 🔗 https://t.co/u6GKal51qM
0
0
0
🥘 Happy #WorldFoodDay! @FAO marks 80 years with the theme “Hand in Hand for Better Foods and a Better Future”, calling for collaboration and cooperation to transform agrifood systems. 🫱🏼🫲🏾 This theme aligns with #EFFoST’s mission to advance sustainable and healthy food for all.
0
0
1
🚨 We are happy to announce that Prof. Paula Bourke will be a plenary speaker at #EFFoST2025! 👉🏼 Don’t miss her session “Innovating in Cold Plasma Processing: Embracing Novelty and Overcoming Challenges! 🔗 Learn more about our speakers: https://t.co/yMyoRIkssO
0
0
0
🚨 Don't miss the @giantleapseu Young Investigators Webinar on Gastrointestinal Digestion & Health! The first webinar of this series will focus on digestion of alternative proteins, in vitro models, nutrient absorption and more. 📍 Free registration: https://t.co/viTf9uusKA
0
1
1
🔏You can still register for the 39th #EFFoST International Conference! The second subtheme explores Sustainable Food Processing and Packaging Innovations 📆17-19 November, 2025 📍Porto, Portugal 🔗 https://t.co/KPIxnUPYsV
0
0
1
✨#EFFoST2025 Sponsors: Elea! With over 250 systems installed worldwide, #ELEA is a global leader in Pulsed Electric Field (PEF) technology. By advancing PEF science and expertise, ELEA continues to power the next generation of food innovation. 🔗 https://t.co/F28AyGUv3y
0
0
0
🤔Why is food processing essential to feeding the world? On World Food Day, nutrition scientists together with @IUFoST are joining forces to talk about the importance of food processing. 📆 October 16, 2025 🔗 https://t.co/s5i4mpqDql
0
0
0